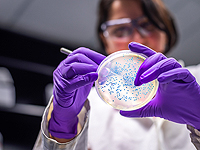
Гипотеза канадских ученых: рак может передаваться через микробиом

Здоровье
adv_09 rimma_dw_d
adv_10 rimma_dw_m
В связи с коронавирусом в Китае и Гонконге продлены школьные каникулы
В Гонконге и на материковом Китае не начнутся занятия в школах, детских садах и высших учебных заведениях после окончания новогодних каникул. Это решение было принято в связи с ускорением распространения коронавируса, которым заразились уже около двух тысяч человек и 56 из них умерли.
adv_11 ca_instrip_direct
Число заразившихся новым типом коронавируса в КНР за сутки увеличилось на треть
Власти Китая сообщают, что число граждан этой страны, заразившихся новым типом коронавируса увеличилось до 1975 человек, 56 из них умерли. Соответствующее уведомление было распространено государственным комитетом КНР по вопросам здравоохранения.
Минздрав: от осложнений, вызванных вирусом гриппа, скончались 40 израильтян
Согласно данным минздрава, с начала зимнего сезона от осложнений, вызванных вирусом гриппа, скончались не менее 40 израильтян. В больницах находятся около 330 человек в тяжелом состоянии. Среди госпитализированных 12 беременных женщин и 75 детей в возрасте до 9 лет.
CNN: в США зарегистрирован первый случай заболевания новым китайским вирусом
По информации телеканала CNN, в США зарегистрирован первый случай заболевания, вызванного "китайским коронавирусом". Телеканал передал, что Центр по контролю и профилактике заболеваний готовится сделать официальное заявление по этому поводу.
Китай подтвердил четвертую смерть от коронавируса: количество больных приближается к 300
Чжон Наньчан, глава Национального комитета по здравоохранению КНР, подтвердил гибель четверых человек, ставших жертвами быстро распространяющегося коронавируса. К настоящему моменту количество заболевших граждан страны приближается к тремстам.
adv_12 ca_instrip_direct
Здоровье ::
25 Января 2020 г.